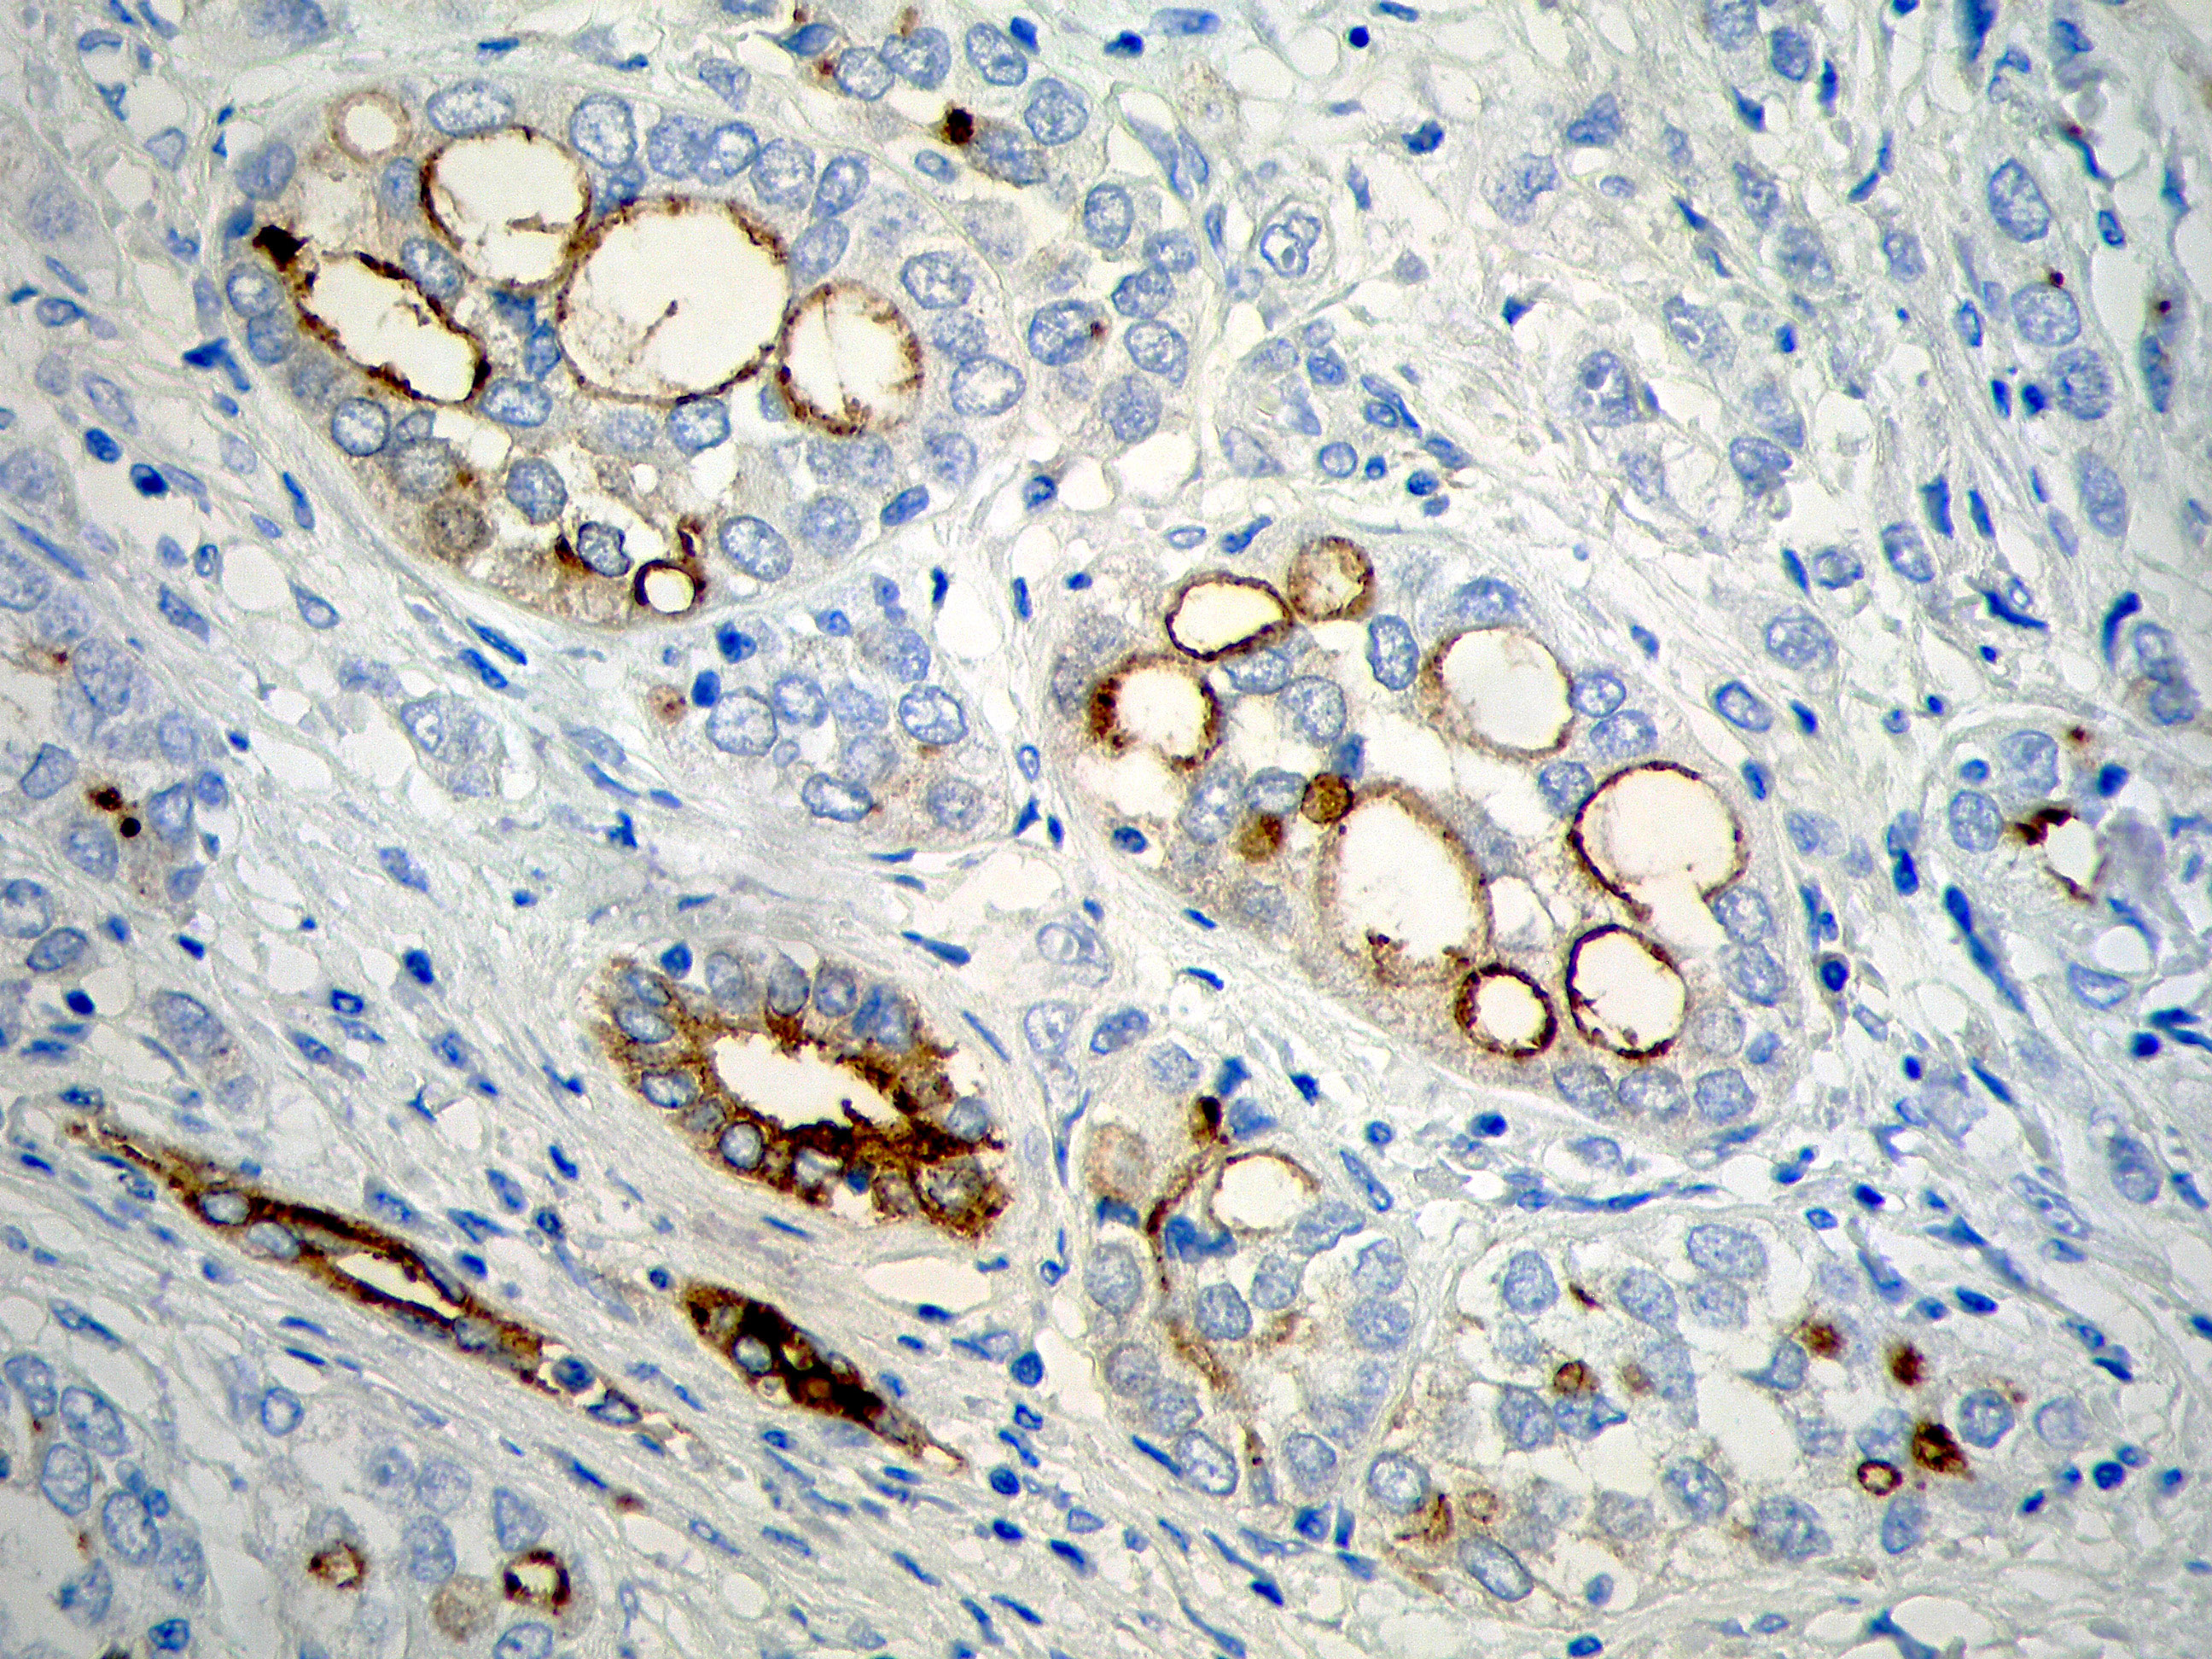

Imágenes en Urología
Carcinoma medular renal.
Valencia-Guadalajara V.Ja, Onrubia-Pintado J.Ab, Martínez-Cayuelas La, Sarrió-Sanz Pa, Sánchez-Caballero L, Gómez-Pérez, Lc, Sánchez Díaz Ad.
a: Servicio de Urología Hospital Universitario de San Juan, Alicante, España. Médico Interno Residente. b: Servicio de Anatomía Patológica Hospital Universitario de San Juan, Alicante, España. Médico Adjunto. c: Servicio de Urología Hospital Universitario de San Juan, Alicante, España. Médico Adjunto. d :Servicio de Urología Hospital Universitario de San Juan, Alicante, España. Jefe del Servicio.
El carcinoma medular renal es una variedad de tumor renal muy infrecuente, diagnosticándose en fase avanzada metastásica y presentando un pronóstico nefasto a corto plazo. No existen directrices claras acerca de su manejo por la escasa evidencia sobre esta entidad. Presentamos un caso de un paciente afecto de carcinoma medular renal.